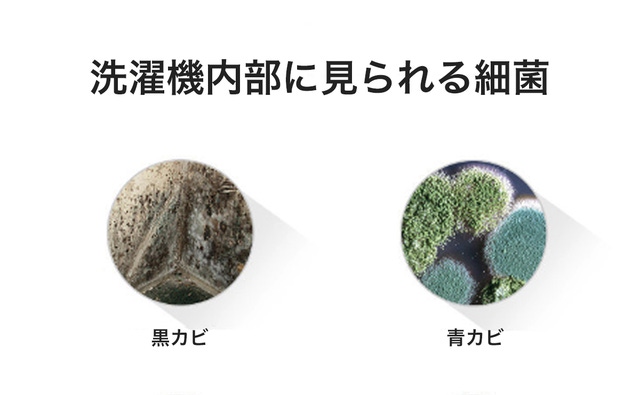

プロジェクト実行者
ストーリー
- 洗剤・柔軟剤使用量を50%~70%削減!洗濯に最適な水質へ変化させるマイクロボール!
- 残留塩素を見逃さない!塩素除去機能付きで敏感肌にも優しい。家族も笑顔に。
- 節水率33%以上!マイクロボールを入れるだけで、環境にもお財布にも優しい。
まだ、真水で洗濯しているのですか?

まだ洗剤と柔軟剤を使っているのですか?
マイクロランドリーボールがあれば洗剤と柔軟剤が不要!
マイクロレベルの洗浄水を生成して汚れを落とすことができます。
ーーーーーーーーーーーーーーーーーーーー
※リターン品の配送が完了するまで、Ehi(実行者)はWell Tradingco.ltd.(メーカー)の日本における独占販売権を有する正規代理店です。
※詳細に関しては、ページ下部のリスク&チャレンジをご確認ください。
ーーーーーーーーーーーーーーーーーーーー
残留洗剤の実態
通常通りに洗剤や柔軟剤を入れて洗濯をすると、多くの残留洗剤が付着します。
残留物が多く残っている服を、今あなたは着ているのを知っていましたか?
残留洗剤テスト

残留蛍光増白剤テスト

青く光っているのが残留物の実態です。
私達が着ている服は、こんなに多くの化学物質を吸い込んでいるのです。

水道水に含まれる塩素や、すすぎ残しの洗剤をまとめて除去!
敏感肌の方でも肌にやさしくご使用いただけます。

マイクロランドリーボールを入れるだけで、残留塩素がきれいに除去されます。
あなたの悩み

悩み、即解決!

※すすぎ回数を1回にすることで、33%節水することができます。
5つの機能

内部構造

洗剤使用時との比較

マイクロランドリーボールの力で、こんなにもきれいに洗濯することができます。
※余洗いをしてから洗濯しています
※汚れがひどい場合は余洗いをしてからご利用ください
洗浄力のヒ・ミ・ツ

マイクロランドリーボールの界面活性分子が、汚れ分子を囲み、隔離してきれいに除去します。
コーヒー汚れも◯

国家認定機関にて洗浄力、柔軟性、漂白力などのテストを完了した製品です。
コーヒーやキムチといった、しつこい汚れも、きれいに洗浄することができます。
※余洗いをしてから洗濯しています
※汚れがひどい場合は余洗いをしてからご利用ください
洗剤コスト削減と節水効果


1,000回繰り返し使用可能で、洗剤のコストを削減できます。
また、すすぎの過程を減らせることで、節水効果もあります。
人にも環境にも優しい製品です。
洗濯槽の汚染除去

洗剤使用量を減らすことができる為、残留洗剤による洗濯槽の汚染を防ぐことができます。
洗濯槽の汚れも徹底除去!
あなたの洗濯機も細菌に汚染された水で、すすぎを行っている可能性があります。
「マイクロランドリーボール」なら、洗濯槽を清潔な状態に保つ事ができます。

洗濯槽の外側には洗剤かすやゴミなどが溜まってしまい、各種細菌の発生につながります。

マイクロランドリーボールを使用することで、ゴミの発生を防ぎ、細菌から守ってくれます。
残留塩素を除去

内蔵された残留物除去ボールが、水道水の残留塩素を除去し、より清潔な水で洗濯物をすすいでくれます。

マイクロランドリーボールを入れるだけで、色付けされた残留塩素がきれいに除去されました。
使用方法
・洗剤・柔軟剤使用量について
洗濯物5kg以下でマイクロボールを1つ、5kg以上の場合は2つ入れて下さい。

通常の投入量を100%として「洗剤は50~30%」「柔軟剤は50%」程の量を入れて下さい。
汚れの度合、洗濯量、ご自身のお好みで投入量を調整して下さい。
※マイクロボールのみ入れて洗濯することも可能です。一般的な洗濯よりも、洗浄効果は下がる場合がございますので、基本的には洗剤を入れてることを推奨しています。
・マイクロランドリーボール使用方法

マイクロボールを使用すると洗剤・柔軟剤使用量が減ります。ですので、「すすぎを1回」にすることを推奨しております。
※すすぎを1回にすることで、使用水量を33%減らす事ができます。
Q&A

・洗濯物5kg以下でマイクロボールを1つ、5kg以上の場合は2つ入れて下さい。
・洗剤や柔軟剤を入れずに、マイクロボールのみ入れて洗濯することも可能です。
・洗濯物の汚れ具合を見て、洗剤・柔軟剤の使用量を調整して下さい。通常の50%~70%の洗剤使用を推奨しています。
・洗剤使用量が減ることで、すすぎ回数や水量を減らすことが可能です。すすぎ回数を1回にすることを推奨しています。
・全ての洗濯機で洗濯が可能です。脱水時も入れたまま使用が可能です。
・ドラム式洗濯機等での熱を加える乾燥を行うと、マイクロボールが傷んだり、熱変形する場合がございます。ご使用はお控えください。
※日本未上陸の輸入製品になります。場合によっては、パッケージ等が英語になる可能性がございます。日本語の説明書を同封しますので、ご安心下さい。
こんな方におすすめ!

応援購入一覧
洗濯物5kg以下でマイクロボールを1つ、5kg以上の場合は2つ入れて下さい。

プロジェクト実行者

「Innovation in electronic habits」
-電子デバイスに関する小さな行動や習慣に着目し、イノベーションを起こします-
現在は電磁デバイスだけではなく、生活に関わる全ての製品の開発に携わっています。
私たちは、少人数精鋭で組織されている [プロジェクトチームEhi]です。日本未上陸最先端のプロダクトをいち早くキャッチし、流通を広げています。現在、アジアのシリコンバレーと言われる深センのメーカーと手を組み、自社ブランド・輸入事業を行なっております。
メーカーの想い
Well Tradingco.ltd.は、韓国で設立された企業になります。主に便利グッズや日用品を欧州圏に輸出している企業になります。

リスク&チャレンジ
プロジェクトに関する情報 ・プロジェクトの属性:輸入商品 ・代理店によるサポート:代理店による、日本語カスタマー対応、保証等 ・プロジェクト実行者:Ehi ・製品国:韓国 ・製造国:韓国 ※日本未上陸の輸入製品になります。場合によっては、パッケージ等が英語になる可能性がございます。日本語の説明書を同封しますので、ご安心下さい。 ※並行輸入品が発生する可能性があります。正規以外での個人輸入等は、完全に防ぐことができない場合がございます旨、予めご了承のほどお願いいたします。 ※リターン品の配送が完了するまで、Ehi(実行者)はWell Tradingco.ltd.(メーカー)の日本における独占販売権を有する正規代理店です。 並行輸入品が発生する可能性がございますが、並行輸入品には正規代理店による製品サポートを受けることができません。 また正規代理店を通じて購入することで、日本国内での流通に必要な各種認証の取得や、関税の適切な処理が担保されます。 ※一部国内に類似品が出回っている場合がございます。弊社では他社の類似品に関してのお問い合わせには対応できませんのでご了承ください。 ※本文中に記載させていただいたスケジュールは、あくまでプロジェクト公開時点の予定です。応援購入の性質上、配送遅延のおそれがございます。 ※原則として、配送遅延に伴う応援購入のキャンセルはできませんが、リターン配送予定月から6ヵ月を超えた場合には、希望者に限りキャンセルにて対応させていただきます。 ※使用感等での返品交換は致しかねます。 ※初期不良のみ、返品交換の対象になっております。 ーーーーーーーーーーーーーーーーーーー
サポーターからの応援コメント
文章のトップに戻る
応援購入する
このプロジェクトはAll in型です。目標金額の達成に関わらず、プロジェクト終了日の2023年06月29日までに支払いを完了した時点で購入が成立します。
【超早割23%OFF】マイクロボール×1 1-2人用

5,900円(税込)
○【超早割23%OFF】マイクロボール×1 1-2人用
洗濯物5kg以下でマイクロボールを1つ、5kg以上の場合は2つ入れて下さい。
○定価(7700円)
○特別価格(5900円)
※デザイン・仕様は変更になる可能性もございます。ご了承ください
*商品到着は9月末を予定しておりますが、製造でのトラブル、コロナによる輸送の遅れ、検品、梱包等の状況等により予定がずれ込む可能性がありますのでご理解ください。
*任意の位を四捨五入し、パーセンテージを表記しています。
【早割17%OFF】マイクロボール×1 1-2人用

6,400円(税込)
○【早割17%OFF】マイクロボール×1 1-2人用
洗濯物5kg以下でマイクロボールを1つ、5kg以上の場合は2つ入れて下さい。
○定価(7700円)
○特別価格(6400円)
※デザイン・仕様は変更になる可能性もございます。ご了承ください
*商品到着は9月末を予定しておりますが、製造でのトラブル、コロナによる輸送の遅れ、検品、梱包等の状況等により予定がずれ込む可能性がありますのでご理解ください。
*任意の位を四捨五入し、パーセンテージを表記しています。
【マクアケ割14%OFF】マイクロボール×1 1-2人用

6,600円(税込)
○【マクアケ割14%OFF】マイクロボール×1 1-2人用
洗濯物5kg以下でマイクロボールを1つ、5kg以上の場合は2つ入れて下さい。
○定価(7700円)
○特別価格(6600円)
※デザイン・仕様は変更になる可能性もございます。ご了承ください
*商品到着は9月末を予定しておりますが、製造でのトラブル、コロナによる輸送の遅れ、検品、梱包等の状況等により予定がずれ込む可能性がありますのでご理解ください。
*任意の位を四捨五入し、パーセンテージを表記しています。
【2セット早割20%OFF】マイクロボール×2 ファミリー用

12,300円(税込)
○【2セット早割20%OFF】マイクロボール×2 ファミリー用
洗濯物5kg以下でマイクロボールを1つ、5kg以上の場合は2つ入れて下さい。
○定価(15400円)
○特別価格(12300円)
※デザイン・仕様は変更になる可能性もございます。ご了承ください
*商品到着は9月末を予定しておりますが、製造でのトラブル、コロナによる輸送の遅れ、検品、梱包等の状況等により予定がずれ込む可能性がありますのでご理解ください。
*任意の位を四捨五入し、パーセンテージを表記しています。
【2セットマクアケ割17%OFF】マイクロボール×2 ファミリー用

12,800円(税込)
○【2セットマクアケ割17%OFF】マイクロボール×2 ファミリー用
洗濯物5kg以下でマイクロボールを1つ、5kg以上の場合は2つ入れて下さい。
○定価(15400円)
○特別価格(12800円)
※デザイン・仕様は変更になる可能性もございます。ご了承ください
*商品到着は9月末を予定しておりますが、製造でのトラブル、コロナによる輸送の遅れ、検品、梱包等の状況等により予定がずれ込む可能性がありますのでご理解ください。
*任意の位を四捨五入し、パーセンテージを表記しています。
【4セット早割22%OFF】マイクロボール×4 ファミリー用

24,000円(税込)
○【4セット早割22%OFF】マイクロボール×4 ファミリー用
○定価(30800円)
○特別価格(24000円)
※デザイン・仕様は変更になる可能性もございます。ご了承ください
*商品到着は9月末を予定しておりますが、製造でのトラブル、コロナによる輸送の遅れ、検品、梱包等の状況等により予定がずれ込む可能性がありますのでご理解ください。
*任意の位を四捨五入し、パーセンテージを表記しています。
【4セットマクアケ割19%OFF】マイクロボール×4 ファミリー用

24,800円(税込)
○【4セットマクアケ割19%OFF】マイクロボール×4 ファミリー用
○定価(30800円)
○特別価格(24800円)
※デザイン・仕様は変更になる可能性もございます。ご了承ください
*商品到着は9月末を予定しておりますが、製造でのトラブル、コロナによる輸送の遅れ、検品、梱包等の状況等により予定がずれ込む可能性がありますのでご理解ください。
*任意の位を四捨五入し、パーセンテージを表記しています。
「Makuake(マクアケ)」は、実行者の想いを応援購入によって実現するアタラシイものやサービスのプラットフォームです。このページは、 プロダクトカテゴリの 「【入れるだけでOK】新感覚のマイクロウォーターで徹底洗浄!繊維の奥までスッキリ♪」プロジェクト詳細ページです。







